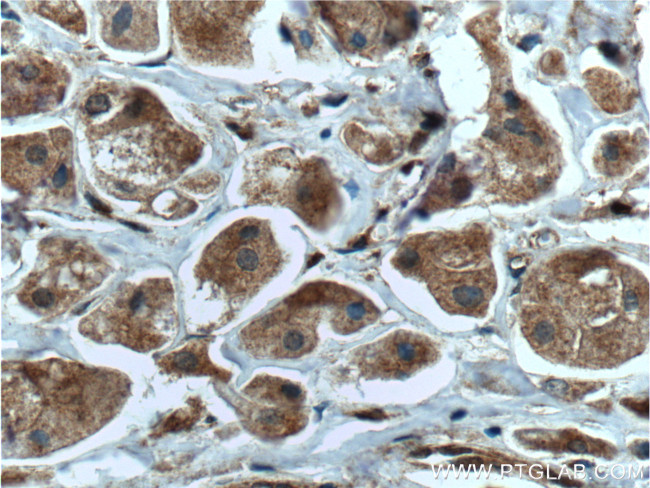
DUSP7/PYST2 Antibody in Immunohistochemistry (Paraffin) (IHC (P))
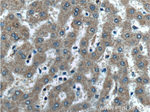
DUSP7/PYST2 Antibody in Immunohistochemistry (Paraffin) (IHC (P))

Search
Proteintech
DUSP7/PYST2 Polyclonal Antibody
{{$productOrderCtrl.translations['antibody.pdp.commerceCard.promotion.promotions']}}
{{$productOrderCtrl.translations['antibody.pdp.commerceCard.promotion.viewpromo']}}
{{$productOrderCtrl.translations['antibody.pdp.commerceCard.promotion.promocode']}}: {{promo.promoCode}} {{promo.promoTitle}} {{promo.promoDescription}}. {{$productOrderCtrl.translations['antibody.pdp.commerceCard.promotion.learnmore']}}
产品信息
26910-1-AP
种属反应
已发表种属
宿主/亚型
分类
类型
抗原
偶联物
形式
浓度
规格
纯化类型
保存液
内含物
保存条件
运输条件
产品详细信息
Immunogen sequence: IRSIIPNHA DKERFATRCK AATVLLYDEA TAEWQPEPGA PASV (60-102 aa encoded by BC104880)
靶标信息
DUSP7 is a member of the dual specificity protein phosphatase subfamily. These phosphatases inactivate their target kinases by dephosphorylating both the phosphoserine/threonine and phosphotyrosine residues. They negatively regulate members of the mitogen-activated protein (MAP)kinase superfamily (MAPK/ERK, SAPK/JNK, p38), which are associatedwith cellular proliferation and differentiation. Different members of the family of dual specificity phosphatases show distinct substrate specificities for various MAP kinases, different tissue distribution and subcellular localization, and different modes of inducibility of their expression by extracellular stimuli.
仅用于科研。不用于诊断过程。未经明确授权不得转售。
生物信息学
蛋白别名: Dual specificity protein phosphatase 7; Dual specificity protein phosphatase MKP-X; Dual specificity protein phosphatase PYST2; MAP kinase phosphatase
基因别名: AU015694; DUSP7; mkp-X; MKPX; PYST2
UniProt ID: (Human) Q16829, (Mouse) Q91Z46, (Rat) Q63340
Entrez Gene ID: (Human) 1849, (Mouse) 235584, (Rat) 300980